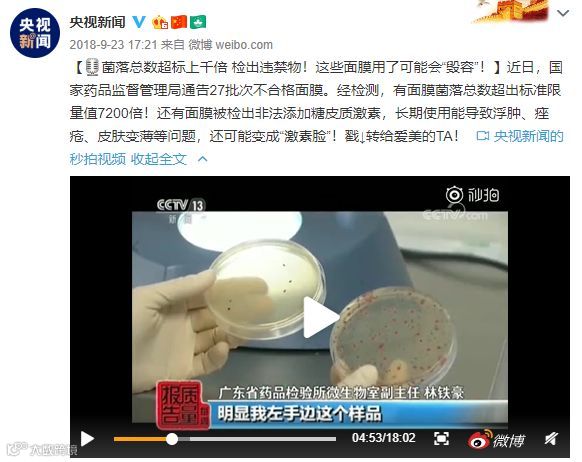

进入九月天气开始转凉,这天气一凉吧,人就开始放松了,有时候洗完澡只想赶紧躺着,护肤步骤能省就省,连刘星都比我精致。

小时候看到这一集的时候,真的是笑到捶地,女孩子偷用妈妈的化妆品就算了,刘星一大老爷们偷敷面膜是怎么回事儿?而且敷完之后还撕不下来了。

当时只是觉得好笑,没想到还真有「敷了就撕不下来的面膜」?
刷到这个视频,吓得我赶紧敷了一片面膜压压惊
事情是这样的,国外一女孩买了一张1.99美元的面膜,敷完之后面膜像胶水一样牢牢地粘在脸上,怎么都撕不下来,看得我头皮发麻!
按理说14块钱的面膜也不算廉价,但这姑娘还是狠狠地踩了个鱼雷...

其实三无面膜出来害人已经不是一次两次了,之前药监局就查处过一批激素含量超标的劣质面膜,连央视新闻都报道过。
这些劣质面膜对皮肤造成的伤害根本不是一两天就能解决的,严重的甚至要去医院治疗(PLMM到底做错了什么)...
所以你们买面膜的时候一定要擦亮眼睛!毕竟我们美丽的脸蛋不是别人的试验田!
刚好现在是面膜畅销的季节,泉泉今天就来给你们安利几款自己用过觉得炒鸡好用的面膜,姐妹们一起来种草叭!
第一款:【若泉水磁场复活草保湿蚕丝面膜】
选用进口蚕丝膜材,敷在脸上轻薄隐形,玩手机人脸识别都没问题。精华液渗透的非常快,沙漠复活草迅速给肌肤补充水分。不管你是干燥肌还是熬夜肌,用一片皮肤就肉眼可见的水润!

同样的进口蚕丝膜材,对于角质层薄、皮肤脆弱容易过敏的MM来说,这绝对是一款必备的面膜。金黄洋甘菊、积雪草、神经酰胺对于易泛红的肌肤效果立竿见影,上海交大技术支持的专利成分“百倍舒”修复肌肤屏障专家,还在等什么赶快用起来!
ps:健康肌肤也可以用,增强肌肤免疫力!!!

都知道漂亮的女人离不开玻尿酸,可是市面上玻尿酸千千万,并不是所有的都用了有效果对肌肤无刺激。表层补水=补水不彻底,若泉家玻尿酸面膜采用的进口三重玻尿酸,大、小、迷你玻尿酸分子各司其职,层层滋养补水,让肌肤喝饱水,每天都是水光肌!

如果你觉得脸上的斑除了激光没办法去掉,那你一定是没用过若泉家这款拥有国家美白特证的面膜。富含烟酰胺和熊果苷,从根源抑制络氨酸酶活性,击退色素沉着。用一周感觉皮肤透亮很多,用一个月雀斑明显淡化,坚持使用暗沉、斑点通通瓦解,轻松拥有嫩白无暇肌!



